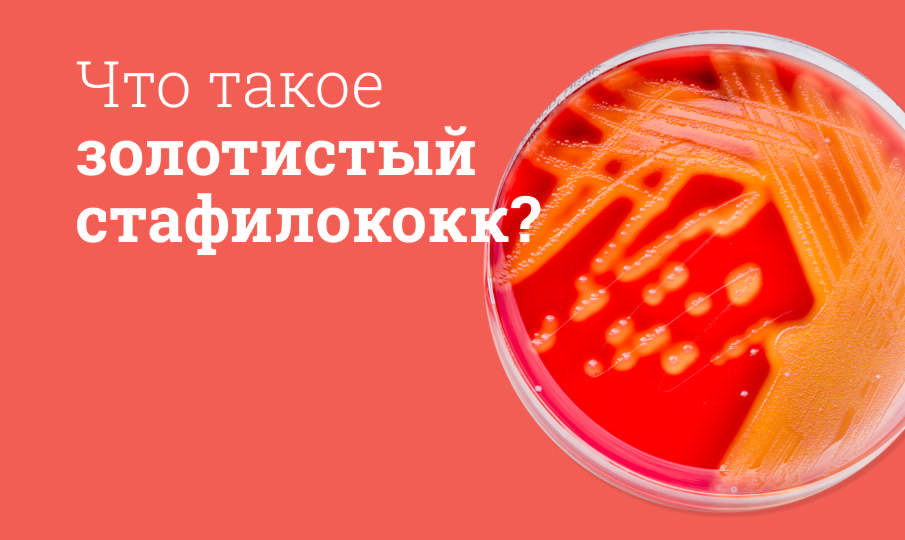

Препараты для лечения костей и суставов
Возраст
Сбросить
Наличие товара
Сбросить
Оригинал/дженерик
Сбросить
Форма выпуска
Сбросить
Дозировка
Сбросить
Первичная упаковка
Сбросить
Фасовка
Сбросить
Объем
Сбросить
СОРТИРОВАТЬ:
По популярности
Рядом
Сустагард Артро концентрат для приготовления раствора для внутримышечного введения 200 мг/мл ампулы 2 мл 5 шт. 
200 мг/мл 5 шт. СО СКЛАДА В 1 аптеке

ФармФирма «Сотекс»
от 1 646 ₽
Крем-бальзам для тела разогревающий Витатека (Vitateka) Сабельник, барсучий жир и красный перец 75 мл 
СО СКЛАДА В 1 аптеке

ООО «Народные промыслы»
от 213 ₽
Дона раствор для внутримышечного введения 200 мг/мл 2 мл ампулы 6 шт. 
200 мг/мл 6 шт. СО СКЛАДА В 1 аптеке

Биологичи Италия Лабораториз С р.л.
от 1 809 ₽
Костарокс таблетки 90 мг 28 шт. 
90 мг 28 шт. СО СКЛАДА В 1 аптеке

Cadila Pharmaceuticals Ltd.
от 1 031 ₽
Костарокс таблетки 120 мг 7 шт. 
120 мг 7 шт. СО СКЛАДА В 1 аптеке

Cadila Pharmaceuticals Ltd.
от 515 ₽
Остео Би-Флекс Rexall Sundown таблетки 40 шт. 
40 шт. СО СКЛАДА В 1 аптеке

Rexall Sundown, Inc.
от 1 831,20 ₽
ВискоПлюс протез синовиальной жидкости 2 мл шприц 1 шт. 
1 шт. СО СКЛАДА В 1 аптеке

Bohus BioTech AB SE
от 10 910 ₽
Виванат Ромфарм раствор для внутривенного введения 1 мг/мл 3 мл шприц 1 шт. 
1 мг/мл 1 шт. СО СКЛАДА В 1 аптеке

К.О. Ромфарм Компани С.Р.Л - Румыния
от 5 442 ₽
Гиалуформ-1-01 материал-гель на основе гиалуроновой кислоты водосодержащий 1% 2 мл шприц 1 шт. 
1% 1 шт. СО СКЛАДА В 1 аптеке

Лаборатория Тоскани
от 6 271 ₽
Инъектран раствор для внутримышечного введения 100 мг/мл ампулы 2 мл 10 шт. 
18 лет+ 100 мг/мл 10 шт. СО СКЛАДА В 1 аптеке

ООО Эллара
от 2 062 ₽
Глюкозамин, хондроитин, МСМ комплекс Solgar таблетки 60 шт. 
18 лет+ 60 шт. СО СКЛАДА В 1 аптеке

Solgar
от 3 131,40 ₽
Статьи по теме:

Почему болит рука от плеча до локтя?
В статье разберемся подробнее
Лечение золотистого стафилококка
Подробнее рассказываем о болезнях, которые вызывает золотистый стафилококк

Алмаг инструкция по применению
Рассказываем о принципе работы и противопоказаниях

Артракам инструкция по применению
Рассказываем о составе, показаниях и особенностях применения

Некст гель инструкция по применению
Подробнее рассказываем о составе, области применения и побочных эффектах

Артра инструкция по применению
Отвечаем на популярные вопросы о препарате








